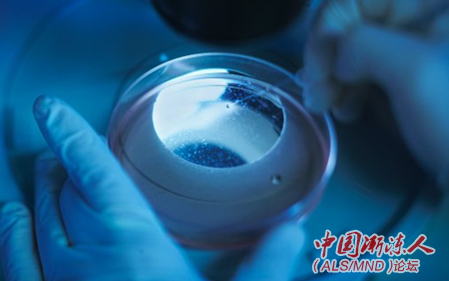
��ϸ��.png

|
Neurology:干细胞治疗ALS可能是安全的 2 T; a+ M$ _( X9 b( A3 I5 T) h( k' N
3 X( l2 L' {( D% p0 {0 {8 m6 n2016年7月01日 讯 /生物谷(译者:尘雾)BIOON/ --一项针对肌萎缩侧索硬化(ALS)患者进行的II期临床试验表明,将人类干细胞植入脊髓可能安全的进行。这项研究2016年6月29日在线发表于美国神经病学学会医学期刊《Neurology》。虽然这项研究并非设计为确定治疗是否有效,但研究人员注意到,治疗没有减缓疾病的进展。 $ O& \& ?9 ~+ H& Q6 F+ L
ALS是一种大脑和脊髓中运动神经元进行性变性退化的疾病。患者会逐渐失去对肌肉的控制能力,包括呼吸和吞咽,最终死亡。目前还没有疗法能够阻止这种疾病的发展。
( @$ B8 E9 z" V

) F. j/ \ ]7 [6 v
“虽然存在两个与治疗有关的严重并发症,但与更良性的疾病相比,治疗ALS患者的可接受风险水平相对较高。”美国神经病学学会成员、埃默里大学医学院神经病学教授Jonathan D. Glass博士说道。
) m% ]! M- t% g2 h- m" a
这项研究在3个大学医院进行,15位ALS患者参与。所有参试患者的初始ALS症状发生都在两年以内。参试者被分成5个治疗组,所接受注射的干细胞剂量逐步增加。这项试验是非盲的,意味着参试者知道他们所接受的是活跃的干细胞治疗。
8 t. O& N) G5 Q: Q$ |7 S# A

7 C9 g- r8 a; I
所有参试者都接受了颈椎(C3和C5之间区域)脊髓的双侧注射。最后一组患者通过两次独立的外科手术同时接受了腰椎(L2-L4)和颈椎脊髓的干细胞注射。注射数量范围为10到40次,注入的细胞数量范围为200万到1600万。在9个月的随访期间,研究人员收集了关于副作用的信息,同时使用ALS功能评定量表测量了参试者的病情发展状况。
2 N7 @$ I5 J- S4 p' k! s! L
大部分副作用与手术相关暂时痛苦和抑制免疫系统的药物有关。两位参试者发展出与治疗有关的严重并发症。一位出现脊髓肿胀,导致疼痛、感觉丧失和部分瘫痪,另一位出现中枢性疼痛综合症。
' f% {* `7 P q; k! I
研究人员将参试者的功能与3个历史对照组进行对比,相对于没有接受治疗的患者,接受干细胞注射的患者在疾病发展速度方面没有差异。不过,Glass警告道,不应该从小型研究得出治疗有效性的结论。 4 O" ^5 H1 d$ f8 z. J. A

- Y$ r8 w# b! F3 V1 `3 S" K+ H8 z
“这项研究并非设计为确定(治疗)延缓或停止ALS发展的有效性,规模也不足以确定疗法有效性。这项研究的重要性在于,它将允许我们推进到规模更大的试验,而更大规模的试验将特定设计为测试人类干细胞植入脊髓对ALS患者是否具有积极的治疗意义”Glass说道。(生物谷Bioon.com)
5 @ h& ]5 S/ z9 O0 ]; ~
本文系生物谷原创编译整理,欢迎转载!点击 获取授权 。更多资讯请下载生物谷APP. 1 n; s( S9 Z- }1 d* V2 Y

* g% ?: O, D; T; B, @8 v* B' Q% _DOI:10.1212/WNL.0000000000002889 http://www.neurology.org/content/early/2016/06/29/WNL.0000000000002889 Transplantation of spinal cord–derived neural stem cells for ALS Objective:?To test the safety of spinal cord transplantation of human stem cells in patients with amyotrophic lateral sclerosis (ALS) with escalating doses and expansion of the trial to multiple clinical centers. Methods:?This open-label trial included 15 participants at 3 academic centers divided into 5 treatment groups receiving increasing doses of stem cells by increasing numbers of cells/injection and increasing numbers of injections. All participants received bilateral injections into the cervical spinal cord (C3-C5). The final group received injections into both the lumbar (L2-L4) and cervical cord through 2 separate surgical procedures. Participants were assessed for adverse events and progression of disease, as measured by the ALS Functional Rating Scale–Revised, forced vital capacity, and quantitative measures of strength. Statistical analysis focused on the slopes of decline of these phase 2 trial participants alone or in combination with the phase 1 participants (previously reported), comparing these groups to 3 separate historical control groups. Results:?Adverse events were mostly related to transient pain associated with surgery and to side effects of immunosuppressant medications. There was one incident of acute postoperative deterioration in neurologic function and another incident of a central pain syndrome. We could not discern differences in surgical outcomes between surgeons. Comparisons of the slopes of decline with the 3 separate historical control groups showed no differences in mean rates of progression. Conclusions:?Intraspinal transplantation of human spinal cord–derived neural stem cells can be safely accomplished at high doses, including successive lumbar and cervical procedures. The procedure can be expanded safely to multiple surgical centers. Classification of evidence:?This study provides Class IV evidence that for patients with ALS, spinal cord transplantation of human stem cells can be safely accomplished and does not accelerate the progression of the disease. This study lacks the precision to exclude important benefit or safety issues.
0 D# {' }& a8 u$ \2 q
* L7 M) d! q! P3 y! v6 s, L. E( A | 


 发表于 2016-7-1 19:05:38
发表于 2016-7-1 19:05:38

发表于 2016-7-1 19:25:33
发表于 2016-7-1 19:25:33


 发表于 2016-7-1 23:21:32
发表于 2016-7-1 23:21:32

 楼主
楼主




 7 O6 M; n# l& y5 W$ T* Y' _. D
7 O6 M; n# l& y5 W$ T* Y' _. D